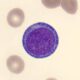
¿Qué es un proeritroblasto?

La otitis externa es un trastorno que se manifiesta con otalgia, acompañada a menudo de prurito y exudado purulento. Se puede hallar como resultado de una exposición reciente al agua (como el caso de la otitis externa aguda u oído de nadador), o traumatismos mecánicos (como rascado o uso de aplicadores de algodón).
La otitis externa suele ser causada por bacilos gramnegativos (como Pseudomonas, Proteus) u hongos (como Aspergillus) que proliferan cuando hay exceso de humedad.
Puede tratarse de un padecimiento grave y persistente en personas con diabetes o inmunosupresión, una mala evolución puede transformarse en osteomielitis de la base del cráneo, lo que se denomina otitis externa maligna.
La osteomielitis observada en la otitis maligna externa es causada generalmente por Pseudomonas aeruginosa, la infección regularmente comienza en el suelo del conducto auditivo y se va extendiendo al suelo de la fosa media, a la lámina cuadrilátera del esfenoides e incluso hasta la base de la mitad contralateral del cráneo.
Manifestaciones clínicas
A la exploración física e instrumentada del conducto auditivo externo podemos hallar eritema y edema de la piel del meato auditivo, un cuadro más avanzado mostrará un exudado purulento.
La manipulación del pabellón auricular suele causar dolor debido a la inflamación de la zona.
En la observación con otoscopio, se puede hallar una superficie externa del tímpano con eritema, la movilidad es normal al observarse con el otoscopio neumático. En ocasiones cuando la piel del meato está muy eritematosa, puede ser imposible observar el tímpano.
La otitis externa maligna por lo común aparece en personas con inmunodeficiencias o diabetes mellitus…
Se manifiesta inicialmente por secreción persistente y fétida del oído, granulaciones en el conducto auditivo, otalgia profunda y, en casos avanzados, parálisis progresiva de pares craneales como VI, VII, IX, X, XI o XII.
El diagnóstico de otitis externa maligna se confirma al demostrar erosión ósea en la tomografía computarizada y en el gammagrama con radionúclidos.
Tratamiento
- Proteger el oído de la humedad.
- Evitar una lesión mecánica por rascado o por intento de limpieza profunda.
- Humidificar el interior del oído.
- Se debe acidificar el conducto con un secante (mezcla de alcohol isopropílico/vinagre blanco a partes iguales).
- En caso de infecciones se usan las gotas óticas acidas de antibióticos que contengan un aminoglucósido o una fluoroquinolona.
- Puede usarse corticoesteroides junto con los antibióticos (como sulfato de neomicina o de polimixina B e hidrocortisona).
- Se debe eliminar con suavidad los residuos purulentos que llenan el meato auditivo para permitir que penetre el fármaco tópico.
- Deben administrarse cinco o mas gotas tres o cuatro veces al día para que se impregnen en forma profunda.
En el caso de que el edema de la pared del conducto impida la entrada de las gotas en el meato auditivo, se coloca un pabilo para facilitar la introducción del fármaco. - En casos de celulitis del tejido periauricular, se usan las fluoroquinolonas por via oral (ciprofloxacina, 500 mg cada 12 horas por una semana).
- En el tratamiento de la otitis externa maligna debe administrarse un antibiótico con acción contra pseudomonas por varios meses.
- El tratamiento intravenoso puede hacerse con 200 a 400 mg de ciprofloxacina cada 12 horas.
- El tratamiento por vía oral corresponde a ciprofloxacina oral 500 a 1 000 mg cada 12 horas.
- Se continua la antibioticoterapia hasta que la se observe disminución del cuadro inflamatorio, incluso en personas asintomáticas.
- La intervención quirúrgica es necesaria en casos complicados de otitis externa maligna donde puede ser necesaria la debridación del hueso infectado.